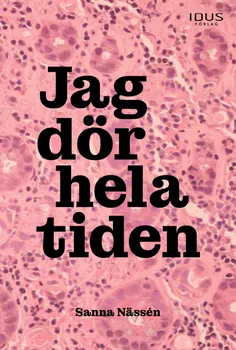

Jag tror jag tänkte att om jag gjorde allt rätt så skulle jag bli belönad. Den där känslan av att ständigt vara jagad skulle försvinna där uppe på platån dit jag alltid var på väg, klättrande upp, uppför bergväggen, i regn och lera och med blodiga knän.
Hon har allt en människa skulle kunna begära. Hon borde vara nöjd, men allt känns fel. Något behöver ändras, frågan är bara vad. Vändpunkten kommer, från ett oväntat håll. Det är cancer. Nu tar livet en helt ny väg. Den är svår och skrämmande, men blir alltmer hennes egen.
Jag dör hela tiden är en roman med självbiografisk grund, en berättelse som är unik men ändå allmängiltig. Med öga för tillvarons talande detaljer och en blandning av ärlig realism och poetiskt utforskande tecknar författaren en berättelse om utveckling, kärlek, sjukdom och friskhet som ifrågasätter, ger nya perspektiv och hopp där det är som mörkast.
Jag dör hela tiden är Sanna Nässéns debutbok.
EPUB3: Reflowable